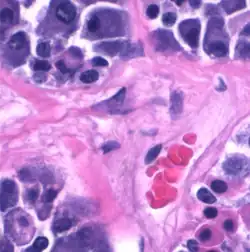

Gonadotrope cel


Gonadotrope cellen (ook wel gonadotropen of gonadotrofen of deltacellen of delta-basofielen genoemd) zijn endocriene cellen in de hypofysevoorkwab, die de gonadotropines produceren, zoals het follikelstimulerend hormoon (FSH) en luteïniserend hormoon (LH). De afgifte van FSH en LH door gonadotrope cellen wordt gereguleerd door het gonadotropine-releasing hormoon (GnRH) uit de hypothalamus.
Gonadotropen lijken basofiel in histologische preparaten.
Gonadotropen hebben insulinereceptoren, die overprikkeld kunnen raken door een te hoog insulinegehalte. Dit kan tot onvruchtbaarheid leiden omdat de niveaus van hormoonafgifte worden verstoord.
Gonadotropesecreties worden geremd door specifieke hormonen zoals estradiol.
Embryologie

Bij muizen begint de organogenese van de hypofyse op embryonale dag 7,5. Op embryonale dag 10,5 wordt het zakje van Rathke gescheiden van het orale ectoderm dat de mond zal vormen. De cellen rond het lumen van het zakje van Rathke zijn ongedifferentieerd en prolifereren actief. Deze cellen migreren naar de buikzijde en vormen de hypofysevoorkwab. Dit is waar de soorten gedifferentieerde cellen verschijnen, inclusief de gonadotrope cellen.[1]
Structuur
Gonadotrope cellen vertegenwoordigen 5-15% van alle cellen van de hypofysevoorkwab. De populatie gonadotrope cellen in de hypofyse vormen een driedimensionaal cellulair netwerk, dat heterogeen en complex is. Dit netwerk van gonadotrope cellen is zowel structureel als functioneel. Het wordt gevormd tijdens de embryonale ontwikkeling en wordt gedurende het hele leven aangepast aan de behoeften. De basale celvernieuwing van de hypofyse is extreem laag; bij de basale mitotische snelheid zijn er tot 10 weken nodig om de gonadotrofe cellen van de volwassen rat te vervangen.[2] Er zijn volwassen voorlopercellen in de hypofyse van gewervelde dieren, die het vermogen hebben om zich te delen en zichzelf te vernieuwen, en vervolgens het vermogen om te differentiëren tot gonadotrofe cellen. Deze stamcellen brengen de transcriptiefactor SOX2 en de hypofysetranscriptiefactor PROP1 tot expressie.[3] Gedurende het postnatale leven kunnen de voorlopercellen op een zeer plastische en dynamische manier differentiëren en bijdragen aan de reeks nieuwe gonadotrofe cellen, gegenereerd als reactie op de fysiologische eisen van de voortplantingscyclus en de zwangerschap.[4]
Netwerkmacroarchitectuur

Driedimensionale netwerken van gonadotrope cellen hebben karakteristieke relaties met andere cellen en met de haarvaten. Deze cellulaire netwerken bestaan uit cellen van hetzelfde type (homotypisch) als cellen van verschillende typen (heterotypisch), die meestal ingebed zijn in bindweefsel en omgeven zijn door uitgebreide netwerken van haarvaten.[5][6][7] Tijdens de levenscyclus zijn er verschillende veranderingen nodig in de hypofysevoorkwab, die permanent of tijdelijk kunnen zijn en plasticiteit worden genoemd. Bij sommige fysiologische processen, zoals de puberteit, is de toename van de activiteit van individuele gonadotrope cellen niet voldoende om aan de behoeften te voldoen en moet er een reorganisatie plaatsvinden in de celpopulatie en in de hypofysestructuur om het volume van de hormoonproductie te vergroten.[8]
- Plasticiteit vindt plaats op cellulair niveau, door regulatie van de celactiviteit door het controleren van de hormoonsynthese en -secretie en door het veranderen van de gevoeligheid van de cellen voor liganden.
- Plasticiteit op het niveau van de gonadotrope celpopulatie vindt plaats door de regulering van het celaantal van elk celtype door de differentiatie van voorlopercellen, de mitose en de fenotypische omzetting van hormoonproducerende cellen te controleren.
- Plasticiteit op het structurele niveau van gonadotrope cellen vindt plaats door de regulering van celmigratie en het vermogen van cellen om cellulaire netwerken te vormen en te hermodelleren.[8]
Structuur onder de lichtmicroscoop
Met de lichtmicroscoop kunnen gonadotrope cellen op basis van hun grootte worden geclassificeerd als "kleine", "middelgrote" en "grote" cellen tussen 8-18 micrometer (μm), waarvan de relatieve percentages veranderingen laten zien tijdens de verschillende stadia van de voortplantingscyclus.[9]
Gonadotrope cellen vertonen basofilie en met hematoxyline-eosinekleuring (H&E) kleuren ze blauwviolet. De gonadotrope cellen lijken afgerond tot veelhoekig en uiteindelijk met lange cytoplasmatische verlengingen. Ze hebben een overvloedig ruw endoplasmatisch reticulum dat hen de karakteristieke kleur geeft en ze hebben ook een overvloed aan celblaasjes en mitochondriën.[10][6]
Structuur onder de elektronenmicroscoop

Op de afbeelding links zijn zichtbaar: De gonadotrope cellen met de kenmerken van polypeptide-uitscheidende cellen. Een ruw endoplasmatisch reticulum met opgezwollen blaasjes. Een groot aantal dichte uitscheidingsblaasjes tussen 300-400 nanometer (nm).[11],[12] De talrijke mitochondriën in het cytoplasma weerspiegelen het hoge energieverbruik.[13] De kernen zijn meestal rond, helder van uiterlijk vanwege het overheersende euchromatine en zijn excentrisch in de cel geplaatst.[14]
De gap junctions zijn zichtbaar, die de communicatie tussen cellen bevorderen en reguleren, waardoor de reacties van de verbonden cellen en daarmee de gonadotrope uitscheidingsfunctie worden gecoördineerd.[15][16]
Hormoonproductie

Gonadotrofe cellen synthetiseren, slaan op en scheiden de hormonen FSH en LH uit, die bestemd zijn voor hun verwante endocriene klieren: de geslachtsklieren. Het concept van trofische hormonen (van het Griekse τροφικός troficos 'voedsel' of 'voeding') illustreert het idee dat het hormoon de doelcel van het naast gelegen orgaan 'voedt' en de groei en functie van deze cellen controleert.[17] De trofische hormonen van de hypofyse regelen de groei en functie van de bijbehorende endocriene klieren.[18]
Bij ratten, varkens en schapen hebben immunocytochemische onderzoeken het bestaan aangetoond van verschillende subpopulaties van gonadotrope cellen, die monohormonaal (LH-cellen of FSH-cellen) of bihormonaal (LH- en FSH-cellen) zijn. Ongeveer 80% van de gonadotrope cellen brengt zowel LH als FSH tot expressie.[6]
- ↑ Majumdar S., Farris CL., Kabat BE., Jung DO., Ellsworth BS., 2012, Forkhead Box O1 Is Present in Quiescent Pituitary Cells during Development and Is Increased in the Absence of p27Kip1, PLoS ONE, 7, 12, e52136 [1], geraadpleegd op 26 november 2021
- ↑ Florio T. (2011). «Adult Pituitary Stem Cells: From Pituitary Plasticity to Adenoma Development». Neuroendocrinología (en inglés) (Karger) 94: 265-277. Geraadpleegd op 1 december 2021 [2].
- ↑ Camilletti M.A.; Martinez Mayer J.; Vishnopolska S.A.; Perez-Millan M.I. (2021). «From Pituitary Stem Cell Differentiation to Regenerative Medicine». Frontiers in Endocrinology (REVISIÓN). Neuroendocrine Science. Geraadpleegd op 2021.[3]
- ↑ Karine Rizzoti; Haruhiko Akiyama; Robin Lovell-Badge (2013). «Mobilized Adult Pituitary Stem Cells Contribute to Endocrine Regeneration in Response to Physiological Demand». Cell Stem Cell 13 (4): 419-432. Geraadpleegd op 29 november 2021[4].
- ↑ Tissier P.R.; Hodson D.J.; Lafont C.; Fontanaud P.; Schaeffer M.; Mollard P. (2012). «Anterior pituitary cell networks». Frontiers in Neuroendocrinology (REVISIÓN) 33 (3): 252-266. Geraadpleegd: 26 november 2021.[5]
- ↑ a b c Clay C.M.; Cherrington B.D.; Navratil A.M. (2021). «Plasticity of Anterior Pituitary Gonadotrope Cells Facilitates the Pre-Ovulatory LH Surge». Frontiers in Endocrinology (REVISIÓN). Neuroendocrine Science. Geraadpleegd: 30 november 2021.[6]
- ↑ Budry L.; Lafont C.; El Yandouzi T.; Chauvet N.; Conéjero G.; Drouin J.; Mollard P. (2011). «Related pituitary cell lineages develop into interdigitated 3D cell networks». PNAS 108 (30): 12515-12520., Geraadpleegd: 4 december 2021.[7]
- ↑ a b Fontaine R.; Ciani E.; Haug T.M.; Hodne K.; Ager-Wick E.; Baker D.M.; Weltzien F-A. (2020). «Gonadotrope plasticity at cellular, population and structural levels: A comparison between fishes and mammals». General and Comparative Endocrinology, (Elsevier) 287: 113344. Geraadpleegd: 30 de november 2021.[8]
- ↑ Childs G.V., Hyde C., Naor Z., Catt K., Heterogeneous luteinizing hormone and follicle-stimulating hormone storage patterns in subtypes of gonadotropes separated by centrifugal elutriation, Endocrinology, 1983, 113, 6, 2120-2128, doi= 10.1210/endo-113-6-2120 [9]
- ↑ Shlomo Melmed. Tratado de endocrinología; Auchus R.J.; Goldfine A.B.; Koenig R.J.; Rosen C.J. (2021). «cap7:Neuroendocrinología». Williams. Tratado de endocrinología. Elsevier Health Sciences. p. 161-163., geraadpleegd: 26 november 2021.[10]
- ↑ Kühnel, Wolfgang (2005). Atlas color de citología e histología. Ed. Médica Panamericana. ISBN 978-84-7903-835-9. Consultado el 3 de diciembre de 2021.[11]
- ↑ Iwama Y. (1990). «Immunohistochemical Identification of Mouse Adenohypophysial Gonadotropes». Okajimas Folia Anat. Jpn. (PDF) 67 (4): 281-288.[12]
- ↑ Shlomo Melmed. Tratado de endocrinología; Auchus R.J.; Goldfine A.B.; Koenig R.J.; Rosen C.J. (2021). «cap7:Neuroendocrinología». Williams. Tratado de endocrinología. Elsevier Health Sciences. p. 161-163. Consultado el 26 de noviembre de 2021.[13]
- ↑ Thomas JEZIOROWSKI, Tsuyoshi WATANABE, Gerhard BARGSTEN and Dietrich GRUBE (1997). «Heterogeneity of Pituitary Gonadotrope Cells in Male Rats». Arch. Histol. Cytol. (PDF) 60 (4): 355-370.[14]
- ↑ Hodson D.J.; Legros C.; Desarménien M.G.; Guérineau N.C. (2015). «Roles of connexins and pannexins in (neuro)endocrine physiology». Cellular and Molecular Life Sciences 72: 2911-2928. Geraadpleegd op 3 december 2021[15].
- ↑ Vitale M.L.; Pelletier R.M. (2018). «The anterior pituitary gap junctions: potential targets for toxicants». Reprod. Toxicol. 79: 72-78. Geraadpleegd op 3 december 2021[16].
- ↑ Silverthorn D.H. (2008). «7:Introducción al Sistema Endócrino». Fisiologia humana: Un enfoque integrado (4a. edición). Médica Panamericana. p. 226. Geraadpleegd op 15 november 2020.[17]
- ↑ Brandan N.C.; Llanos I.C.; Horac F.A.; Tannuri H.O.; Rodríguez A.N. (2014). Principios de Endocrinología (en inglés). Universidad Nacional del Nordeste, Facultad de Medicina, Cátedra de Bioquímica. Geraadpleegd op 15 november 2020.[18]